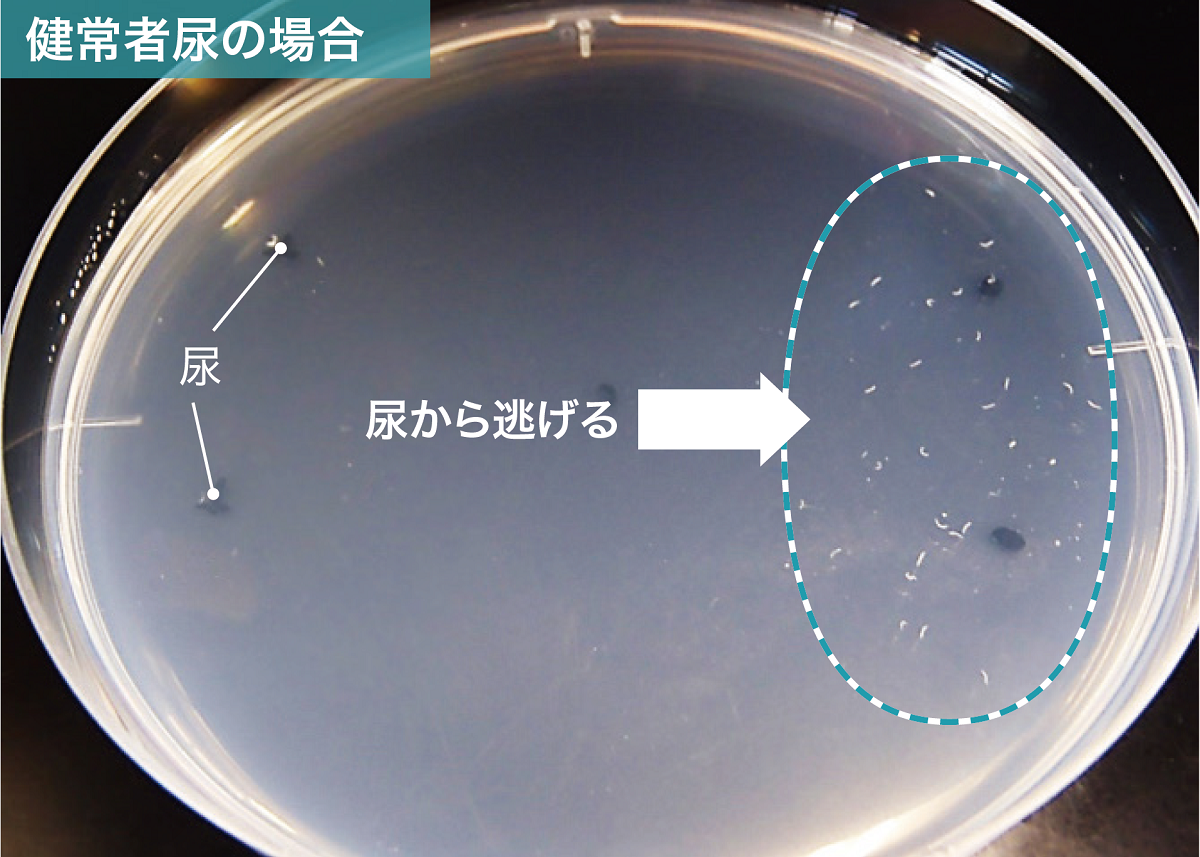
線虫がん検査」実用化は予定通りに、次はすい臓がん向け“特殊線虫”も

マイストア
変更
お店で受け取る
(送料無料)
配送する
納期目安:
2025.12.17 10:34頃のお届け予定です。
決済方法が、クレジット、代金引換の場合に限ります。その他の決済方法の場合はこちらをご確認ください。
※土・日・祝日の注文の場合や在庫状況によって、商品のお届けにお時間をいただく場合がございます。
N-NOSE 線虫ガン検査 HIROTSU BIO SCIENCE 世界初!がんのリスク早期発見サービス「N-NOSE®」 田中麗奈さん出演のの詳細情報
世界初!がんのリスク早期発見サービス「N-NOSE®」 田中麗奈さん出演の。HIROTSUバイオサイエンス | 線虫がん検査に関する世界最先端の線虫行動。楽天市場】【ふるさと納税】 年内発送 ! (12/24 決済完了分まで) がん。ご覧いただきありがとうございます。。2枚目の写真をご覧ください私宛の宛名の部分を剥がしたのですが、あまりきれいに剥がせておらずごめんなさい。テスラ缶大 Tesla MedBed Generator。線虫がん検査」実用化は予定通りに、次はすい臓がん向け“特殊線虫”も。未開封です。2025年の3月に届きました。【新品未開封】タニタ innerScan DUAL 体組成計。InBody H20B ホワイト 体脂肪計・体組成計。検体提出は1ヵ月以内を推奨していますと書いてありますが、1ヵ月以上経ってももちろん問題なく検査ができる事は販売元に確認済みです。
ベストセラーランキングです
近くの売り場の商品
カスタマーレビュー
オススメ度 4.4点
現在、4194件のレビューが投稿されています。